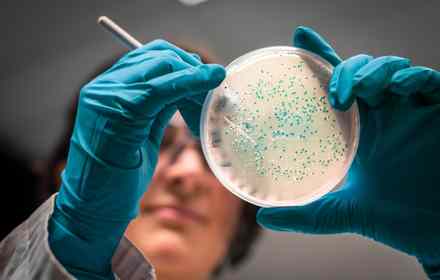

Diagnóstico & Cirurgia Dermatológica
Avaliação, diagnóstico e remoção com técnica refinada.
- Biópsia de lesão cutânea
- Exérese de nevos e tumores benignos
- Exérese com margem oncológica

Excelência em cuidados dermatológicos com tecnologia de ponta.

Conjunto de técnicas e tecnologias voltadas para a melhora global da pele e dos contornos faciais. Atua na firmeza, textura, luminosidade e suavização dos sinais do tempo de forma integrada.
O protocolo é definido de forma personalizada, combinando diferentes abordagens para promover resultados naturais, progressivos e alinhados às características de cada paciente.

Tecnologia a laser de última geração para rejuvenescimento e melhora da qualidade da pele. Atua em diferentes camadas, estimulando colágeno, promovendo firmeza e renovação cutânea de forma progressiva.
Protocolo versátil, indicado para tratar flacidez, textura irregular e sinais do envelhecimento, com resultados naturais e recuperação rápida.

Tecnologia que combina microagulhamento com radiofrequência para atuar em camadas profundas da pele, estimulando colágeno e promovendo melhora da firmeza e da textura.
Indicado para flacidez, poros dilatados, cicatrizes e irregularidades, com resultados progressivos e naturais, respeitando a estrutura e as características de cada paciente.

Tecnologia de ultrassom microfocado que atua nas camadas profundas da pele, promovendo estímulo de colágeno e melhora progressiva da firmeza.
Indicado para flacidez e redefinição de contornos, com efeito lifting não cirúrgico e resultados naturais ao longo do tempo.

Tecnologia de radiofrequência fracionada que promove renovação da pele e estímulo de colágeno em diferentes camadas.
Indicado para melhorar textura, flacidez, cicatrizes e qualidade da pele, com recuperação controlada e resultados progressivos.

Técnicas que estimulam a produção natural de colágeno e promovem sustentação da pele, atuando na melhora da firmeza e do contorno
Terapias de estímulo de colágeno promovem resultados progressivos, enquanto os fios de PDO auxiliam na redefinição estrutural, com efeito lifting e aspecto natural ao longo do tempo.

Técnica injetável que estimula a produção natural de colágeno, promovendo melhora progressiva da firmeza, elasticidade e qualidade da pele.
Indicado para tratar flacidez e prevenir o envelhecimento, com resultados graduais e naturais ao longo do tempo, respeitando as características de cada paciente.

Tecnologia que utiliza resfriamento controlado para reduzir gordura localizada de forma não invasiva, promovendo a eliminação gradual das células adiposas.
Indicado para áreas com acúmulo de gordura resistente, contribuindo para melhora do contorno corporal com resultados progressivos e naturais.

Procedimento cirúrgico indicado para correção estética e funcional da região íntima, promovendo maior conforto, simetria e melhora da qualidade de vida.
Realizado com técnicas modernas e abordagem individualizada, respeitando a anatomia de cada paciente e priorizando resultados naturais, com recuperação orientada e segura.

Conjunto de tratamentos voltados para a melhora da qualidade da pele e dos tecidos da região íntima, atuando na firmeza, hidratação e conforto local.
Indicado para alterações relacionadas ao tempo, variações hormonais e pós-parto, com protocolos personalizados que promovem resultados progressivos, naturais e com máxima discrição.

Terapias Corporais Localizadas: Protocolos clínicos minimamente invasivos focados na melhoria estética do contorno corporal, redução de irregularidades e refinamento da silhueta..

Programa intensivo para corrigir mudanças significativas no corpo, como perda de volume, flacidez, redução de massa muscular e alterações na qualidade da pele e queda dos cabelos.
Protocolos personalizados com foco em naturalidade, segurança e tecnologia quando indicada.
Suavização de rugas e reposicionamento de volumes com plano individualizado. Resultado natural, respeitando sua anatomia e expressividade.
Firmeza e textura com tecnologia de estímulo de colágeno, indicada após avaliação. Ideal para flacidez leve a moderada e melhora global da pele.
Protocolo para melhora progressiva de firmeza e contornos, com planejamento por etapas. Acompanhamento para ajuste fino e evolução segura. Para rosto e corpo


Dra. Najla Smaili CRM: 10564/SP
A Dra. Najla Smaili oferece avaliação dermatológica com foco em diagnóstico preciso e plano de tratamento individualizado; da saúde da pele aos procedimentos estéticos e cirúrgicos quando indicados.
Mais do que técnica, o diferencial está na leitura clínica, na escolha responsável da conduta e no acompanhamento por etapas. Aqui, tecnologia entra quando faz sentido; sempre com segurança, naturalidade e orientação clara.
- Conduta baseada em avaliação
- Protocolos com critério médico
- Evolução monitorada
NOSSA FILOSOFIA
Cuidar da saúde da pele é unir ciência aplicada com decisões responsáveis em um plano que faça sentido para sua rotina e seus objetivos.
Aqui, cada conduta começa com avaliação criteriosa e diagnóstico bem definido. Quando a tecnologia é indicada, ela entra como ferramenta (não como promessa). O resultado é um cuidado personalizado, com orientação clara, revisões e ajustes para evoluir com segurança e naturalidade.

Diagnóstico, prevenção e tratamentos com critério médico e plano individualizado.
Avaliação completa da pele, cabelos e unhas com foco em diagnóstico preciso e prevenção de doenças. Conduta individualizada para acne, manchas, alergias, lesões suspeitas e acompanhamento periódico.

Protocolos personalizados para rejuvenescimento, textura, manchas e flacidez, com indicação responsável. Tecnologia aplicada quando necessária, priorizando naturalidade e segurança.

Remoção de lesões benignas e suspeitas com técnica precisa e cuidado estético. Inclui biópsia, exérese com margem de segurança quando indicada e acompanhamento pós-procedimento.

Avaliação e protocolos para queda capilar, alopecia e condições inflamatórias do couro cabeludo. Plano por etapas com acompanhamento para evolução consistente.
Procedimentos e tratamentos individuais organizados por área. Indicações e combinações são definidas em avaliação clínica.
Avaliação, diagnóstico e remoção com técnica refinada.
Procedimentos ambulatoriais, rápidos e seguros.
Planejamento anatômico e resultado natural.
Uniformização, poros e renovação controlada.
Protocolos dedicados para áreas sensíveis.
Firmeza, textura e redução de medidas conforme avaliação.
Observação: a escolha do procedimento e a indicação de combinações dependem de avaliação médica individual. Resultados variam conforme o caso, fototipo, hábitos e adesão ao plano proposto.
Excelência em cuidados dermatológicos com tecnologia de ponta.

Protocolo que combina modulação muscular profilática com renovação celular para máxima luminosidade pré-evento.
Indicado para quem busca viço e aparência mais descansada no pré-evento.

Protocolo de renovação com combinação de peeling e estímulo de textura, com cuidados orientados no pós.
Evolução costuma ser progressiva ao longo dos dias, conforme fototipo e indicação médica.

Associação de técnicas para reestruturação de volumes, relaxamento muscular focal e indução natural de firmeza.
Objetivo: definição sutil e resultado natural, respeitando características do rosto.

Radiofrequência fracionada associada a estímulo de colágeno, conforme indicação, para flacidez leve a moderada.
Firmeza costuma evoluir de forma progressiva com estímulo de colágeno.

Cronograma planejado para quem tem data marcada, combinando procedimentos conforme avaliação e tempo disponível.
Acompanhamento e ajustes são definidos caso a caso.

Protocolo para fortalecimento do couro cabeludo e suporte ao crescimento, conforme avaliação.
Indicação e resposta variam conforme causa e estágio.

Combinação de técnicas para uniformização de tom e melhora de textura, em ambiente privativo.
Conduta definida por avaliação e histórico clínico.

Remoção de lesões benignas selecionadas com foco em cicatriz discreta, conforme indicação.
Técnica e pós-procedimento são orientados individualmente.

Atuação estratégica na musculatura facial para suavização de vincos, preservando a expressividade.
Plano e áreas são definidos pela avaliação.

Combinação de modulação muscular, indutores de firmeza e tecnologias para atuar em diferentes camadas, conforme indicação.
Evolução é progressiva e individual.

Protocolo com múltiplas tecnologias para firmeza, textura e luminosidade, com cronograma planejado.
Indicação e sequência dependem de avaliação clínica.
DEpoimentos
“Fiquei impressionada com o nível de tecnologia e explicação detalhada antes do procedimento. Me senti segura em cada etapa. O acompanhamento pós-tratamento fez toda a diferença no resultado.”
“Optei por um protocolo completo porque queria algo mais estruturado. O planejamento foi minucioso e os resultados vieram progressivamente. Minha pele está mais firme, iluminada e uniforme.”
“O atendimento é extremamente profissional e acolhedor. Tudo é feito com muita técnica, mas também com cuidado humano. É uma experiência diferenciada, não apenas um procedimento estético.”

Endereço: Av. Ibirapuera, 2907 - Cj. 108/109 - Moema, São Paulo - SP, 04029-200
Telefone: (11) 3294-0488
Horário: Seg–Sex 09:00–18:00 • Sáb 09:00–13:00 • Dom Fechado